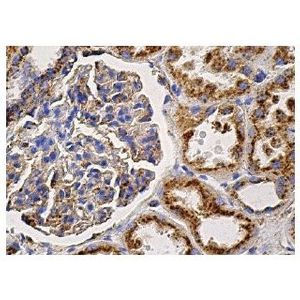
LAMP-2 (H4B4) Alexa Fluor® 488

Product Filters
Search by Category
Products by Company
Popular Keywords
Scientific Products
Discover cutting-edge solutions to scientific challenges with our curated selection of top products from industry-leading companies. From innovative tools to essential equipment and supplies, find everything you need to advance your research on one convenient page.